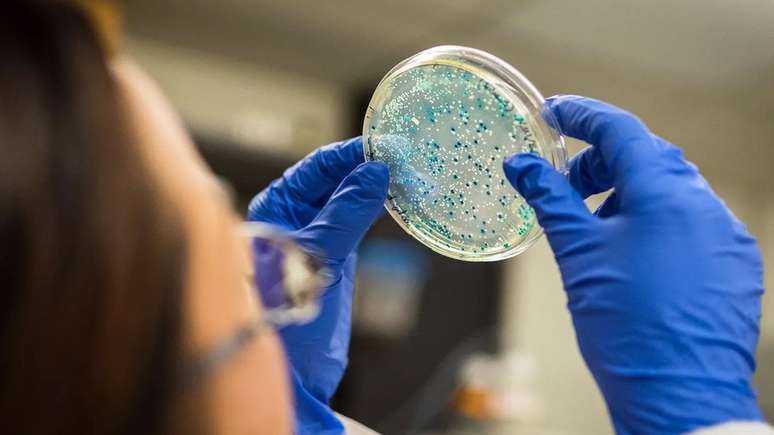
O equilíbrio das bactérias que vivem no nosso intestino pode ter impacto significativo sobre a saúde, com inflamações, doenças intestinais e prejuízo ao nosso sistema imunológico.

Os benefícios do exercício físico para o funcionamento do intestino
Entenda a importância do processo que ocorre no intestino quando você pratica exercícios com frequência
Sabemos que a atividade física melhora a nossa saúde - mas a rica microbiota escondida dentro de nós pode ajudar muito mais do que pensávamos.
O nosso intestino está repleto de vida. Cerca de 100 trilhões de bactérias, vírus, fungos e outros organismos unicelulares, como arqueobactérias e protozoários, disputam espaço e alimento no nosso trato gastrointestinal.
Suas funções vão desde ajudar a fermentar fibras alimentares das nossas refeições até a regulagem do metabolismo da gordura e a síntese de vitaminas. Eles também ajudam a nos proteger contra invasores indesejados, interagindo com o nosso sistema imunológico e influenciando a extensão das inflamações no nosso intestino e em outras partes do corpo.
Estudos já demonstraram que a diversidade desses inquilinos intestinais é menor em pacientes que sofrem de obesidade, doenças cardiometabólicas e condições autoimunes. E existem doenças que foram associadas a quantidades muito grandes ou muito pequenas de certas espécies de bactérias no nosso intestino.
Níveis abaixo do normal de uma das bactérias mais abundantes no intestino de adultos saudáveis (uma bactéria em forma de bastão chamada Faecalibacterium prausnitzii) foram associados a doenças inflamatórias.
Diversos fatores - incluindo nossos genes, os tipos de medicação que tomamos, o estresse que vivenciamos, nossa alimentação e os efeitos causados pelo fumo - podem se associar para alterar o equilíbrio dos micro-organismos no nosso intestino. A composição dessa comunidade interna é, de fato, muito dinâmica.
Mas, da mesma forma que simples escolhas de estilo de vida podem prejudicar nossos micróbios intestinais, também existem decisões que os ajudarão a florescer de forma mais saudável.
Manter alimentação diversificada, incluindo mais de 30 alimentos vegetais diferentes por semana, pode ajudar. Também pode ser benéfico ter uma boa noite de sono e reduzir os níveis de estresse. E, surpreendentemente, passar algum tempo na natureza pode trazer efeitos positivos.
Mas o mais surpreendente é que os exercícios físicos também podem influenciar nossas bactérias intestinais.
Todos nós sabemos que os exercícios trazem benefícios para a nossa saúde física e mental, mas uma corrida após o trabalho pode fazer com que os nossos micróbios do intestino também fiquem em forma?
"O exercício parece afetar nossos micróbios intestinais, aumentando as comunidades bacterianas que produzem ácidos graxos de cadeia curta [SCFAs, na sigla em inglês]", segundo Jeffrey Woods, professor de cinesiologia e saúde comunitária da Universidade de Illinois em Urbana-Champaign, nos Estados Unidos, que estuda os efeitos dos exercícios físicos sobre o corpo humano.
"Os ácidos graxos de cadeia curta são um tipo de ácido graxo produzido principalmente por micróbios e sabe-se que eles modificam nosso metabolismo, imunidade e outros processos fisiológicos", acrescenta Jacob Allen, professor de fisiologia do exercício da Universidade de Illinois, colega de trabalho de Woods.
Estudos em camundongos
Ao longo dos últimos 10 anos, pesquisas voltadas para os animais e os seres humanos ajudaram a revelar como é poderosa essa ligação entre os exercícios físicos e as mudanças da comunidade dos micróbios intestinais. E, o mais importante, elas vêm destacando como esse equilíbrio pode ser benéfico.
Algumas das primeiras indicações podem ser encontradas em estudos sobre os animais. Camundongos que puderam andar voluntariamente em uma roda quando quisessem, por exemplo, desenvolveram quantidades significativamente menores de uma bactéria específica chamada Turicibacter. A presença desta bactéria é associada ao aumento do risco de doenças intestinais, segundo Woods e Allen, que conduziram o estudo.
Já os camundongos sedentários ou que foram suavemente cutucados para incentivá-los a correr apresentaram números muito mais altos da bactéria. Acredita-se que forçar os camundongos a correr tenha causado estresse crônico entre os animais, o que pode anular os efeitos benéficos do exercício.
Os micróbios intestinais nos ratos também parecem ser beneficiados quando eles correm voluntariamente em uma roda. Pesquisadores descobriram que o exercício também parece aumentar os níveis de um ácido graxo de cadeia curta específico chamado butirato, que as bactérias intestinais produzem pela fermentação de fibras e é relacionado a diversos benefícios à saúde.
O butirato tem diversas funções no corpo: é o principal combustível para as nossas células intestinais, ajuda a controlar a função de barreira intestinal e regula inflamações e as células imunológicas do intestino.
O micróbio intestinal Faecalibacterium prausnitzii é considerado uma das principais bactérias responsáveis pela produção de butirato.
Bactérias produtoras de butirato foram associadas a efeitos benéficos sobre o metabolismo em camundongos e seres humanos. Particularmente, quantidades reduzidas de Faecalibacterium prausnitzii foram relacionadas a doenças inflamatórias intestinais, pois sua presença é necessária para que o intestino tome ações anti-inflamatórias.
Diversos estudos recentes com animais indicaram que o exercício físico pode aumentar a quantidade dessas bactérias no intestino dos camundongos.
Em 2018, pesquisadores norte-americanos também concluíram que o transplante de micróbios intestinais de camundongos treinados com exercícios em camundongos livres de germes reduziu o volume de inflamação intestinal nos camundongos que receberam os micróbios.
E o efeito nas pessoas?
Os estudos em animais indicam como os exercícios físicos podem melhorar o equilíbrio dos micróbios do intestino de camundongos. E o que nos dizem os estudos com seres humanos?
Existem certamente muitos estudos em seres humanos que demonstram que exercícios moderados a vigorosos, como correr, andar de bicicleta e exercícios de resistência podem aumentar a diversidade das bactérias intestinais, o que foi relacionado à melhora da saúde física e mental.
Sessões de exercícios aeróbicos de até 18-32 minutos aliadas a exercícios de resistência, três vezes por semana por um total de oito semanas, podem fazer a diferença, segundo indicam os estudos.
Os atletas também costumam ter maior diversidade de micróbios intestinais, em comparação com as pessoas sedentárias. Isso pode também se dever, em parte, às dietas especializadas que os competidores costumam adotar.
Mas diversos estudos demonstraram que a combinação de exercícios e alimentação pode aumentar a população de Faecalibacterium prausnitzii e a produção de butirato em mulheres ativas, muitas vezes com aumento da função intestinal.
"Alguns estudos, mas não todos, demonstraram que o exercício físico aumenta [os níveis de] Faecalibacterium", segundo Woods. Ele acrescenta que pessoas com baixos níveis deste tipo de bactéria parecem ter mais risco de sofrer doença inflamatória intestinal, obesidade e depressão.
Os estudos de Woods e Allen destacaram que sair para correr por 30 a 60 minutos ou um breve exercício na esteira da academia pode trazer impactos sobre a quantidade de bactérias produtoras de butirato no intestino, como Faecalibacterium.
Em um estudo que envolveu 20 mulheres e 12 homens com diversos índices de massa corporal (IMC), Woods e seus colegas tentaram determinar se exercícios aeróbicos por seis semanas poderiam alterar os micróbios intestinais de seres humanos adultos que antes eram sedentários.
Eles pediram aos participantes que fizessem três sessões de exercícios aeróbicos com intensidade moderada a vigorosa por semana, seja correndo na esteira ou andando de bicicleta, por 30-60 minutos.
Amostras de sangue e fezes foram coletadas ao longo de todo o estudo. A alimentação dos participantes foi controlada a cada três dias para garantir sua consistência antes de cada coleta, assim limitando as mudanças causadas pela alimentação sobre os micróbios intestinais.
Suas conclusões demonstraram que a quantidade de "produtores de butirato" aumentou muito com os exercícios, independentemente do índice de massa corporal. E, acompanhando as mudanças na comunidade microbiana, os participantes magros tiveram aumento dos ácidos graxos de cadeia curta, como butirato, nos seus exames de fezes.
É interessante observar que, quando as pessoas que participaram do estudo retornaram ao seu estilo de vida sedentário nas seis semanas seguintes, os pesquisadores descobriram que os micróbios intestinais dos participantes haviam retornado ao seu estado inicial. Esta conclusão indica que, embora o exercício possa melhorar a saúde da comunidade bacteriana no intestino, as mudanças são transitórias e reversíveis.
Outro pequeno estudo, publicado em 2019 por uma equipe liderada pela professora Jarna Hannukainen, do Departamento de Clínica Médica da Universidade de Turku, na Finlândia, observou mudanças mais específicas nos micro-organismos intestinais de 18 participantes sedentários, que haviam sido diagnosticados com diabetes tipo 2 ou pré-diabetes.
Os participantes praticaram exercícios de alta intensidade com intervalos (pedalar por 30 segundos, com quatro minutos de recuperação a cada quatro, cinco e depois seis períodos curtos) ou treinamento contínuo moderado (andar de bicicleta por 40-60 minutos), três vezes por semana, por duas semanas.
Os pesquisadores observaram que as duas formas de exercício aumentaram a quantidade de bactérias Bacteroidetes - um grupo fundamental de bactérias intestinais que participam da decomposição de açúcares e proteínas e induzem o sistema imunológico a produzir moléculas anti-inflamatórias no interior do intestino. Níveis reduzidos dessas bactérias foram associados à obesidade e à síndrome do intestino irritável.
Os exercícios também reduziram os níveis de bactérias Clostridium e Blautia. Acredita-se que estas bactérias, em altos níveis, prejudiquem parte do sistema imunológico, aumentando as inflamações.
De fato, Hannukainen e sua equipe observaram níveis significativamente menores de moléculas indicadoras de inflamações no sangue e no intestino, em participantes que haviam praticado exercícios. Particularmente, havia níveis mais baixos de marcadores inflamatórios conhecidos por se ligarem a lipopolissacarídeos - componentes encontrados nas paredes celulares das bactérias intestinais.
Sabe-se que os lipopolissacarídeos causam inflamações em baixo grau em todo o corpo e também influenciam a resistência à insulina e o desenvolvimento de arteriosclerose - que, por sua vez, aumenta o risco de ataque cardíaco e derrame cerebral.
Hannukainen e seus colegas afirmam que seu trabalho também demonstrou que os exercícios físicos reduziram especificamente as bactérias intestinais associadas à obesidade.
Por que isso acontece?
Woods afirma que ainda não está claro como os exercícios promovem mudanças na comunidade de micro-organismos intestinais, embora haja diversas teorias.
"Quando nos exercitamos, nosso corpo produz lactato, que pode servir de combustível para certas espécies de bactérias", segundo ele.
Woods explica que outro possível mecanismo podem ser as alterações induzidas pelos exercícios no sistema imunológico, especialmente o sistema imunológico intestinal, pois nossos micróbios intestinais estão em contato direto com as células imunológicas do intestino.
Os exercícios físicos também causam mudanças no fluxo sanguíneo para o intestino, que pode afetar as células que revestem as paredes intestinais e, por sua vez, gerar mudanças nos micróbios. Alterações hormonais causadas pelos exercícios também podem causar mudanças nas bactérias intestinais.
Mas nenhum desses possíveis mecanismos "foi definitivamente testado", segundo Woods.
Alguns atletas de elite costumam sofrer estresse induzido por exercícios físicos, devido à alta intensidade dos seus treinamentos. Estimativas indicam que até 20-60% dos atletas sofrem de estresse devido ao excesso de treinamento e recuperação inadequada.
Mas as bactérias intestinais podem ajudar a controlar a liberação de hormônios acionada pelo estresse relacionado aos exercícios e também ajudar a liberar moléculas que melhoram o humor.
Elas podem ainda ajudar os atletas a lidar com certos problemas intestinais, mas são necessárias mais pesquisas neste campo.
Ainda existe muito mais que podemos aprender sobre como nossa atividade física afeta as criaturas que vivem dentro do nosso intestino, como os tipos e a duração dos exercícios que podem alterar a comunidade microbiana.
Essa influência pode também variar de um indivíduo para outro, dependendo do IMC, dos micróbios que moram no intestino de cada um e de outros fatores de estilo de vida, como a alimentação e os níveis de estresse e sono.
À medida que os cientistas continuarem a desvendar os segredos escondidos no nosso trato gastrointestinal, poderemos encontrar novas formas de melhorar nossa saúde com as vibrantes e diversificadas comunidades de organismos que habitam o nosso corpo.
Leia a versão original desta reportagem (em inglês) no site BBC Future.
- Este texto foi publicado em https://www.bbc.com/portuguese/geral-62826557